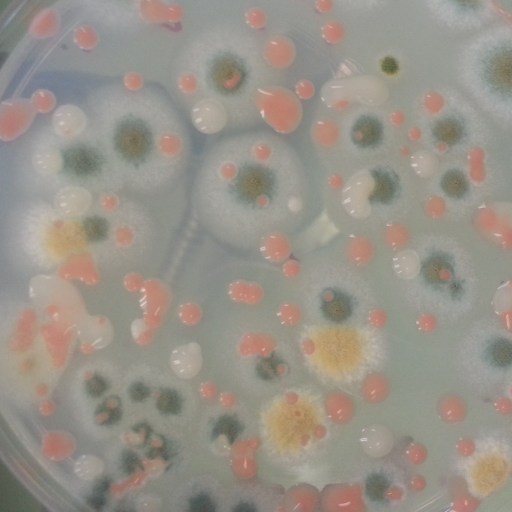

Search
Natalie Shoemaker
Contributing Writer
Natalie has been writing professionally for about 6 years. After graduating from Ithaca College with a degree in Feature Writing, she snagged a job at PCMag.com where she had the opportunity to review all the latest consumer gadgets. Since then she has become a writer for hire, freelancing for various websites. In her spare time, you may find her riding her motorcycle, reading YA novels, hiking, or playing video games. Follow her on Twitter: @nat_schumaker
Read Less

Email takes up a lot of our time and often results in little real work getting done at the end of the work day. Many enterprises are finding the less it’s used, the less time gets wasted. Productivity goes up and stress goes down.

Chefs may be able to start drafting a menu for Mars-bound astronauts. A group of Dutch scientists have found radishes, peas, rye, and tomatoes may take root in Martian soil.

Google’s DeepMind and the Future of Humanity Institute are trying to find a way for human operators to stay in control if artificial intelligence starts acting out.

A group of German researchers are developing a way for robots to process pain. This “artificial robot nervous system” is designed to allow the robots to “feel” and avoid further unwanted stimulus.

Google has announced final design plans for the first modular smartphone, the project Ara. However, Dave Hakkens, who nurtured this idea for a modular device, isn't happy with the final product.

Kickstarter loves games. Since the crowdfunding site’s inception in 2009, Kickstarter has successfully raised $444 million for this category alone.

Breakfast has been made out to be one of the most important meals of the day. It’s taboo to skip it, because of all the wonderful things researchers say this one meal can do to improve our lives. But is breakfast's pedestal deserved?

One study looked at how antibiotics affect the bacteria in our gut and how this, in turn, affects our brains.

Waverly Labs has developed a universal language translator that sits in your ear. It's called the Pilot.

An astronaut looked out the window of the Cupola—an observation nook on the International Space Station (ISS)—and saw a crack in the glass. Imagine floating in space in a pressurized spacecraft and seeing a crack in the thing keeping you safe from the empty void outside.
The International Space Station (ISS) has been playing host to many different kinds of microbes as part of a larger study to figure out how bacteria reacts to a microgravity environment and cosmic radiation.

Every cosmetic cream under the sun promises “a more youthful look” with dubious results. But scientists at MIT may have found a way to bottle a face-lifting cream that smooths out wrinkles.

During a live audio conference, NASA announced the discovery of 1,284 confirmed exoplanets as part of a new method outlined in a recent study. This method may help cut down the busywork of finding habitable planets.

Five of the Solomon Islands have vanished due to rising sea levels. The effects of climate change will be keeping cartographers busy as our borders continue to shift.

What does solar energy adoption look like across America? The cost of solar panels have gone down significantly, but state incentives maybe what's most helping to drive this solar surge.

There's been a lot of talk among Republican candidates Ted Cruz and Donald Trump about completing the United States-Mexico border fence. But completing the wall has consequences outside of human politics.
























